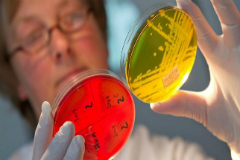

Новости Беларуси
Личный состав органов внутренних дел с 2 по 4 июля переводится на усиленный вариант несения службы. Об этом сообщил журналистам заместитель начальника главного управления - начальник управления охраны правопорядка главного управления охраны правопорядка и профилактики милиции общественной безопасности Министерства внутренних дел Дмитрий Курьян, передает корреспондент БЕЛТА.
До 1 июля - дня, когда в стране состоится деноминация белорусского рубля, остается меньше суток. Как известно, это чисто технический процесс, предполагающий замену денежных знаков образца 2000 года на денежные знаки образца 2009-го (этот год обозначен на банкнотах потому, что они отпечатаны по заказу Нацбанка еще в 2008-м). Номинал новых купюр лишится четырех нолей и уменьшится по сравнению со старыми в десять тысяч раз, то есть нынешние десять тысяч рублей станут одним рублем, а сто рублей - одной копейкой.
"Белпочта" предупреждает об особенностях работы почтовых отделений в связи с деноминацией, сообщили БЕЛТА в пресс-службе компании.
Белорусская железная дорога не будет продавать билеты через интернет утром 28 июня, сообщили БЕЛТА в пресс-центре БЖД.
Система продажи билетов через интернет не будет работать с 7.00 до 8.00. В это время на серверном оборудовании будут проводиться технические работы.
Источник: Белта
Подготовлено предложение об оптимизации численности Миноблисполкома более чем на 20%. Об этом заявил председатель Минского облисполкома Семен Шапиро в эфире программы "Контуры" на телеканале ОНТ, сообщает БЕЛТА.
Министерство здравоохранения и Министерство спорта и туризма рекомендуют гражданам Беларуси временно отказаться от поездок в украинский Измаил из-за осложнения эпидемиологической ситуации, сообщили БЕЛТА в пресс-службе Минспорта.
Планы по созданию предприятий "Полесьекалий" и "Славкалий", о которых говорил Президент Беларуси на Всебелорусском народном собрании, позволят увеличить поступления в бюджет, заявила сегодня журналистам председатель Постоянной комиссии Палаты представителей Национального собрания Беларуси по бюджету и финансам Людмила Добрынина, отвечая на вопрос корреспондента БЕЛТА.
Новые акционеры компании "Уралкалий" регулярно обращаются к Президенту Беларуси по поводу сотрудничества с "Беларуськалием", сообщил сегодня глава государства Александр Лукашенко на пятом Всебелорусском народном собрании, передает корреспондент БЕЛТА.
Министерство здравоохранения пояснило, как после деноминации округлять цены на медицинские товары и другие материалы, используемые при оказании платных медицинских, санитарно-гигиенических услуг. Соответствующее разъяснение размещено на сайте министерства, сообщает БЕЛТА.
График отключения горячей воды у некоторых потребителей столицы опубликован на официальном сайте Мингорисполкома, сообщает БЕЛТА.
Время прекращения подачи горячей воды будет максимально сокращено, в случае успешных испытаний трубопроводов тепловых сетей и отсутствия дефектов, требующих выполнения незапланированных ремонтно-восстановительных работ, не превысит 14 суток.
Во всех школах Беларуси к 2018 году планируется обеспечить широкополосный доступ в интернет, сообщила корреспонденту БЕЛТА начальник управления электросвязи Министерства связи и информатизации Ольга Федореева.
Депутаты Палаты представителей 16 июня приняли в первом чтении поправки в Закон «Об автомобильном транспорте и автомобильных перевозках». В обновленный законодательный акт попадут и ранее применявшиеся, но не закрепленные на таком уровне нормы — например, о том, что пассажир такси имеет полное право не платить за поездку, если водитель не выдал ему чек.
19-летняя жительница Дзержинска размещала на своей странице в социальной сети «Вконтакте» видеозаписи порнографического характера. Несмотря на то, что видео было добавлено еще в феврале прошлого года, это не освобождает нарушительницу от ответственности.
Лечение рака в Беларуси соответствует мировому уровню, заявил министр здравоохранения Василий Жарко во время IX съезда онкологов и радиологов СНГ и Евразии в Минске, передает корреспондент БЕЛТА.
Столичными следователями возбуждено уголовное дело в отношении подростков, подозреваемых в махинациях в сети Интернет.